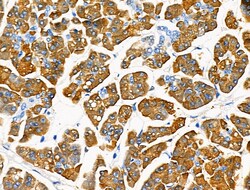
Invitrogen Trypsin Polyclonal Antibody 100 &mu;L; Unconjugated:Antibodies,
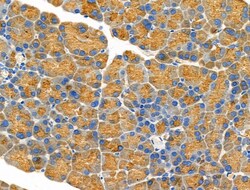
Invitrogen Trypsin Polyclonal Antibody 100 &mu;L; Unconjugated:Antibodies,

missing translation for 'onlineSavingsMsg'
Learn More
Learn More
Invitrogen™ Trypsin Polyclonal Antibody


Rabbit Polyclonal Antibody
Brand: Invitrogen™ PA5106876
This item is not returnable.
View return policy
Description
Antibody detects endogenous levels of total PRSS1.
Trypsin is a 24 kDa enzyme of the serine proteinase family. It is produced in the pancreas as an inactive precursor, trypsinogen, but the active enzyme is located in the gastrointestinal tract where it degrades proteins to large peptides. Trypsin prefers lysine and arginine residues. One of the substrates for trypsin is chymotrypsinogen which is cleaved to produce active chymotrypsin. High levels of immunoreactive trypsin in the bloodstream can indicate pancreatic malfunction and this indicator is used to screene for and diagnose Cystic Fibrosis.
Specifications
| Trypsin | |
| Polyclonal | |
| Unconjugated | |
| PRSS1 | |
| Alpha-trypsin chain 1; Alpha-trypsin chain 2; Anionic trypsin I; anionic trypsin-1; Anionic trypsinogen; beta-trypsin; Cationic trypsinogen; digestive zymogen; MGC120175; MGC149362; nonfunctional trypsin 1; pancreatic trypsin 1; pretrypsinogen I; Protease Serine 1; protease serine 2 preproprotein; protease, serine 1; protease, serine 1 (trypsin 1); protease, serine 2; protease, serine, 1; protease, serine, 1 (trypsin 1); protease, serine, 2; protease, serine, 2 (trypsin 2); PRSS1; PRSS2; PTRYI; RATPTRYI; Serine protease 1; Serine protease 2; TCR V beta 4.1; TRP1; Try1; Try-1; TRY2; TRY4; TRY8; Trygn16; TRYP1; TRYP2; TRYP8; trypsin 1; Trypsin I; Trypsin II; trypsin-1; Trypsin-2; trypsinogen; trypsinogen 1; trypsinogen 16; trypsinogen 2; trypsinogen A | |
| Rabbit | |
| Affinity Chromatography | |
| RUO | |
| 114228, 24691, 5644 | |
| -20°C | |
| Liquid |
| Immunohistochemistry (Paraffin), Western Blot, Immunocytochemistry | |
| 1 mg/mL | |
| PBS with 50% glycerol and 0.02% sodium azide; pH 7.4 | |
| P00762, P07477 | |
| PRSS1 | |
| A synthesized peptide derived from human PRSS1(Accession P07477), corresponding to amino acid residues V71-A121. | |
| 100 μL | |
| Primary | |
| Human, Mouse, Rat | |
| Antibody | |
| IgG |
Product Content Correction
Your input is important to us. Please complete this form to provide feedback related to the content on this product.
Product Title
Spot an opportunity for improvement?Share a Content Correction